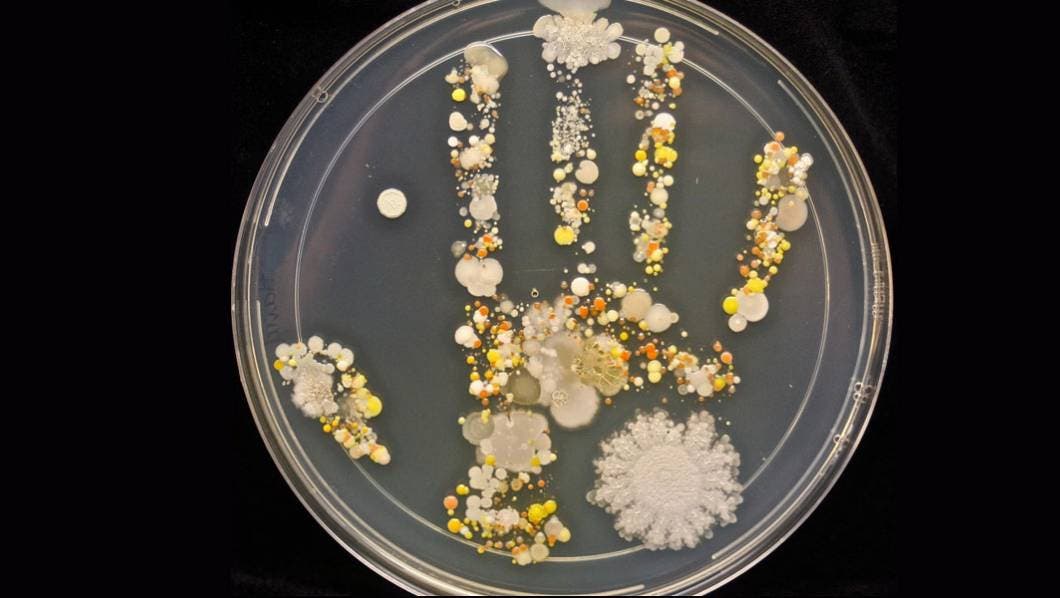

La exposición a microbios también puede proteger contra la obesidad, la diabetes tipo 2 y las alergias, revelan recientes investigadores.
Así, dejar que los lactantes se ensucien un poco durante su primer año de vida, o incluso durante sus primeros meses, puede ayudar a evitar problemas como obesidad, diabetes tipo 2 y asma, indican microbiólogos de la Universidad de Columbia Británica (UBC).
Los científicos han sabido por años que ciertos microbios ayudan a fortalecer el sistema inmunológico. Sin embargo, investigadores de la UBC están haciendo énfasis en qué tan rápido comienza este proceso y cómo los médicos pueden ayudar a prevenir enfermedades al exponer a los lactantes a ciertos microbios.
"Menos de un año de vida es cuando parece haber un profundo efecto en cómo se desarrollan los microbios y cómo afectan la forma en que se desarrolla nuestro sistema inmunológico, lo cual afectará posteriormente si somos propensos a padecer asma o alergias", dijo Brett Finlay, microbiólogo de la UBC.
A finales de este año, Finlay y su coautora Marie-Claire Arrieta pronto publicarán un libro sobre este tema, el cual se titula Let Them Eat Dirt: How Our Quest for Clean is Making Our Children Sick.
Según indica Finlay, la protección microbiana contra enfermedades comienza desde el embarazo. Por ejemplo, los niños que nacen por cesárea son 20% más propensos a padecer asma.
Sin embargo, nuevas investigaciones hacen énfasis en microbios específicos que afectan este proceso. Se puede evitar que los niños desarrollen asma si se les expone a cuatro bacterias intestinales específicas antes de que cumplan tres meses, señala el trabajo de Finlay.
Dicho descubrimiento puede ser la clave para evitar que se padezca asma en su totalidad. "Quizá si administramos estos cuatro microbios, podemos corregir el asma".
Finlay refiere que ideas de los tiempos modernos, como lavarse las manos con frecuencia, pueden contribuir con altas tasas de lo que algunos científicos llaman enfermedades "occidentales" en países desarrollados.
"Obesidad, diabetes tipo 2, asma, alergias, enfermedad intestinal inflamatoria. Todos estos padecimientos se dispararán en términos de instancias en nuestra sociedad".
La gente podría aprender acerca de algunas cosas que hacían sus familiares de más edad, señaló.
"Si pensamos cómo vivimos y cómo criamos a nuestros hijos hoy en día, y lo comparamos con la forma en que nuestros bisabuelos criaron a sus hijos, nos podemos dar cuenta de que vivimos en un mundo muy diferente en términos de exposición microbiana".
Pero renunciar a jabón de manos antibacterial y no esterilizar los juguetes de los niños no significa que la gente deje de lado medidas de salud importantes como las vacunas. "Las vacunas son una gran medida de salud pública", dijo Finlay.